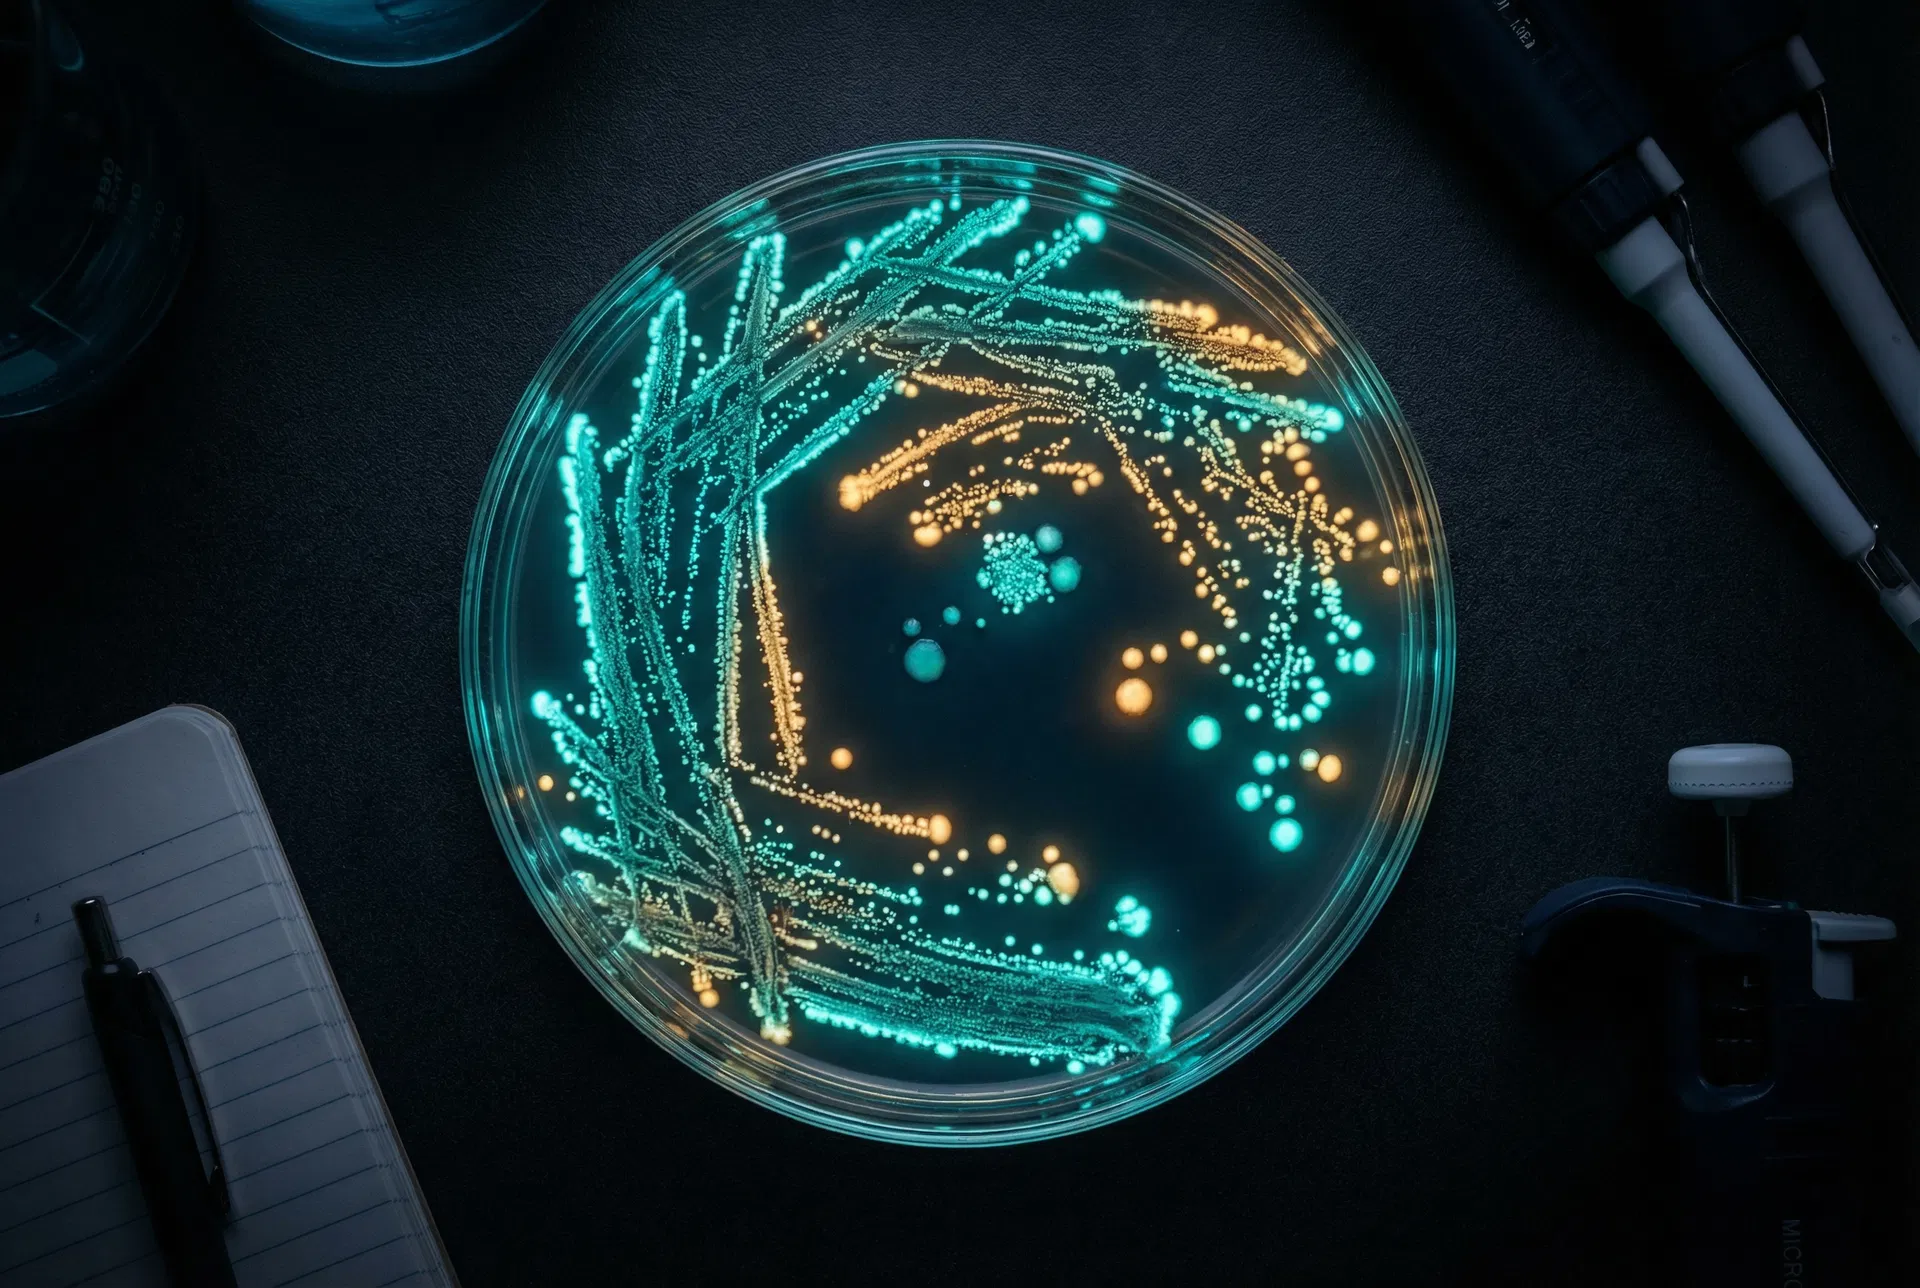
The Gram Stain: 140 Years of Diagnostic Power

The Silent Pandemic: Understanding Antibiotic Resistance
Antimicrobial resistance is one of the greatest threats to global health. Here's what's happening at the molecular level — and why it matters more than ever.


Antimicrobial resistance is one of the greatest threats to global health. Here's what's happening at the molecular level — and why it matters more than ever.

With an estimated 10^31 phages on Earth, bacteriophages are the most numerous biological entities on the planet. Their biology is as fascinating as their therapeutic potential.

Antimicrobial resistance is one of the greatest threats to global health. Here's what's happening at the molecular level — and why it matters more than ever.

With an estimated 10^31 phages on Earth, bacteriophages are the most numerous biological entities on the planet. Their biology is as fascinating as their therapeutic potential.
Developed by Hans Christian Gram in 1884, the Gram stain remains one of the most important diagnostic tools in clinical microbiology. Here's the chemistry behind it.